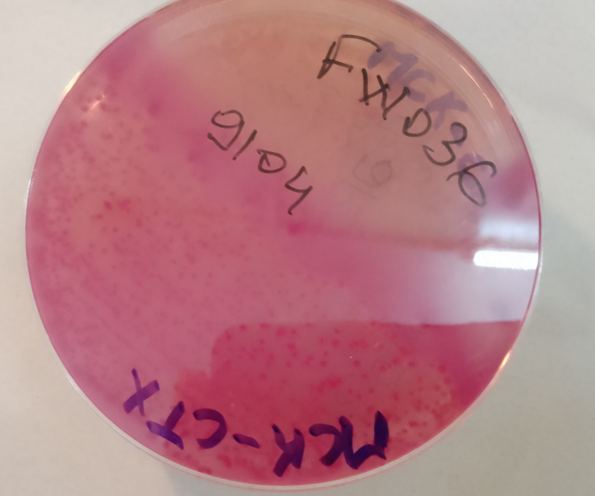
3

PROJET TRICYCLE
Description
Le projet TRICYCLE, lancé par l’OMS en 2017, vise à surveiller longitudinalement et de manière trans-sectorielle l’antibiorésistance, en se concentrant notamment sur Escherichia coli productrice de bêtalactamases à spectre élargi (BLSE). Il propose un protocole standardisé pour recueillir la prévalence des E. coli-BLSE dans les secteurs humain, animal et environnemental, permettant ainsi d’avoir une vision globale de l’antibiorésistance. Le Burkina Faso a adopté ce protocole et a commencé sa mise en œuvre effective en janvier 2024, sous la coordination du LNR_RAM et de la DLBM.
OBJECTIF DU PROJET
Assurer une surveillance intégrée de la RAM à travers la recherche de E. coli BLSE dans les 3 principaux secteurs : santé humaine, santé animale et l’environnement au Burkina Faso.
Découvrez notre
Implication
- Appuyer techniquement les différents sectoriels
- Analyser les échantillons des différents sectoriels pour la ville de Bobo-Dioulasso
- Assurer la conservation des souches
- Assurer la confirmation des identifications, la réalisation des antibiogrammes et l’analyse moléculaire des souches
- Assurer la diffusion des résultats
Quelques images illustratives

Investigateur PRINCIPAL
Pr Abdoul-Salam OUEDRAOGO
Investigateur principal